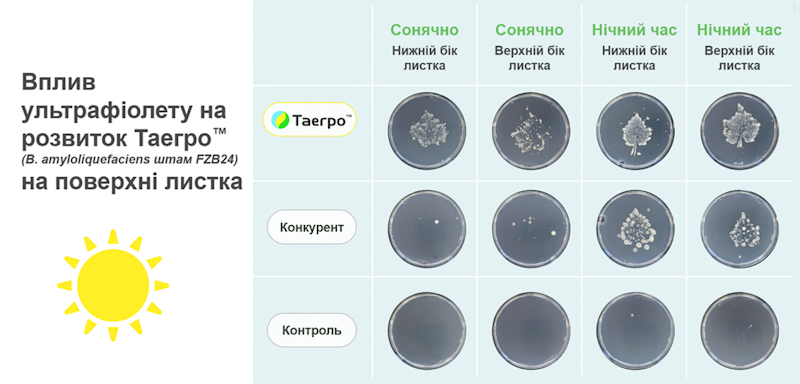

Botrytis повсюдний і здатний уражувати всі надземні частини рослини — листя, стебла, квітки та плоди. Зараження відбувається в періоди високої вологості, передусім через місця механічних пошкоджень, тріщини або рани від обрізки. Спори гриба можуть лишатися в стані спокою до 12 тижнів у місцях проникнення й проростають, коли рослина в стресі. Особливо небезпечною є здатність патогену швидко поширюватися в умовах підвищеної вологості в теплицях. При цьому втрати врожаю від сірої гнилі можуть сягати 30–40%, що суттєво впливає на економічну ефективність виробництва.
Традиційно для боротьби з цим захворюванням застосовують хімічно синтезовані фунгіциди, але в умовах закритого ґрунту його контроль ускладнюється досить розтягнутим у часі періодом збирання плодів томатів й огірків, що значно обмежує можливості використання хімічних засобів захисту рослин через установлені терміни очікування. Крім того, підвищена стурбованість щодо залишків пестицидів у харчових продуктах, розвиток резистентності патогенів і посилення екологічних норм створюють додаткові виклики для виробників і спонукають їх шукати альтернативні методи захисту рослин, які повинні бути ефективними проти патогену і водночас безпечними для використання безпосередньо перед та під час збирання врожаю.
Саме тому у відповідь на потреби ринку компанія «Сингента» представляє інноваційний біологічний фунгіцид Таегро™. В основі цього препарату — унікальний штам Bacillus amyloliquefaciens FZB24, який належить до високоефективних бактерій проти гнилей, борошнистої роси, альтернаріозу, фітофторозу, бактеріальних хвороб на різних овочевих і садово-ягідних культурах. Штам FZB24 з погляду характеристик істотно вирізняє Таегро™ з-поміж інших рішень на ринку. Завдяки продукуванню «штамспецифічних» ліпопептидів і полікетидів, що мають потужну супресивну дію проти широкого спектра шкодочинних грибів і бактерій, Таегро™ забезпечує надійний захист рослин і сприяє підвищенню їхньої стійкості до патогенів.
Головні переваги препарату
• Контактна і профілактична дії на збудника сірої гнилі (Botrytis cenerea);
• Контроль сірої гнилі в період повної стиглості плодів та ягід;
• Збереження якісних показників завдяки запобіганню випаровуванню вологи з поверхні плодів та ягід;
• Побічний контроль борошнистої роси, різних гнилей, альтернаріозу, бактеріальних хвороб;
• Короткий термін очікування — 0 днів;
• Можливе використання в органічному вирощуванні;
• Безпечний для людей, комах-запилювачів та навколишнього середовища;
• Використання в антирезистентних програмах;
• Надійний партнер у бакових сумішах;
• Відсутність фітотоксичності;
• Зручна упаковка — на 1 га;
• Висока концентрація діючої речовини — нижча норма витрати.
Механізм дії
Таегро™ забезпечує комплексний захист рослин завдяки трьом головним механізмам дії.
1. Біопротекторна дія (конкуренція на поверхні листка). Після потрапляння на рослину бактерії Таегро™ починають активно ділитися, утворюючи на поверхні густу мережу ланцюжків колоній, що перешкоджають зараженню та поширенню збудника. Вони створюють тимчасовий фізичний бар’єр, який блокує розвиток патогенів і бактерій, що можуть досягти рослинної поверхні. Саме тому важливо, щоб колонії бактерій Таегро™ утворилися на рослині до зараження патогенними грибами.

2. Вироблення фунгіцидних метаболітів. У процесі росту й розмноження бактерії Таегро™ виробляють потужні антимікробні сполуки — ліпопептиди (сурфактин, ітурин, фенгіцин) та полікетиди (бацилен, диффицидин, макролактин). Ці метаболіти активно пригнічують ріст і розвиток патогенних грибів та бактерій, забезпечуючи додатковий рівень захисту.

3. Активація захисних механізмів. Бактерії Таегро™ індукують сигнальні ланцюги та виділення специфічних білків (PR2, PR8) рівномірно по всій рослині, внаслідок чого запускаються механізми, що перешкоджають проникненню та поширенню шкодочинних грибів у тканини рослин. Науково цей механізм називається SAR (системна набута резистентність). Це забезпечує підвищення загальної стійкості рослини до широкого спектра патогенів навіть у частинах рослини, які не були безпосередньо оброблені препаратом.

Екологічна адаптивність
Однією з головних переваг Таегро™ є його висока адаптивність до різних умов навколишнього середовища. Штам FZB24 ефективно працює в широкому діапазоні температур і рівнів pH, є стійким до змивання опадами та дії УФ випромінювання, що забезпечує стабільну ефективність препарату в різних кліматичних умовах і на різних етапах розвитку культури.
• Температура
Оптимальна температура застосування препарату варіює від +15 до 45 °С, що дозволяє використовувати Таегро™ у вирощуванні культури в теплицях. За нижчих температур бактерії Таегро™ розмножуватимуться, але повільніше.
• Рівень рН
Таегро™ чудово адаптується до широкого діапазону рН, що гарантує вищий рівень біологічної активності. Оптимальний рівень рН робочого розчину — від 5 до 9.
• Стійкість до змивання
Таегро™ має відмінні властивості щодо утримання на поверхні рослин навіть за рясного поливу чи опадів. Підвищена вологість, роса і легкі опади сприятливі для поділу, заселення ендоспор Таегро™ та їх метаболічної діяльності проти збудників хвороб. Опади <20 мм суттєво не впливають на концентрацію бактерій Таегро™ на поверхні рослини й на ефективність дії проти патогенів. Проте за сильних опадів (понад 20 мм) слід провести додаткову обробку.

• Вплив світла
Хоч Таегро™ не чутливий до ультрафіолету й може витримувати високі рівні сонячного випромінювання, однак листкова поверхня після нанесення препарату швидко висихає й тим самим зменшується активність колонізації. З огляду на це в умовах відкритого ґрунту рекомендовано застосовувати Таегро™ у вечірні або ранкові години, щоб скористатися росою або високою вологістю на листках.
• Сумісність
Завдяки тому, що бактерії в Таегро™ перебувають у формі виживання — ендоспор, препарат можна змішувати з більшістю хімічних засобів захисту рослин, включаючи мідь (для підсилення захисту від бактеріозів) та сірку (для підвищення ефективності проти борошнистої роси).

Безпека та екологічність
Біологічна природа Таегро™ забезпечує високий рівень безпеки для людей, корисних комах і навколишнього середовища. Препарат не має періоду очікування перед збиранням урожаю, що дозволяє застосовувати його навіть у період дозрівання та збирання плодів. Це є особливо цінним для контролю післязбиральних захворювань і збереження якості продукції під час зберігання й транспортування.
Застосування
Що ж до особливостей застосування Таегро™, то найвищий рівень ефективності цей продукт демонструє в поєднанні з хімічним захистом у рамках інтегрованих систем, гарантуючи отримання продукції, яка відповідає вимогам якості й безпечності. Якщо ж говорити про органічне вирощування, то для забезпечення максимального захисту культури важливо підтримувати постійну концентрацію бактерій Таегро™ на листковій поверхні. Цього можна досягти, дотримуючись інтервалів між обробками. Залежно від умов навколишнього середовища, швидкості росту рослин та ризику розвитку захворювань такі інтервали мають бути від 5 до 10 діб, проте не більше як 12 діб.
Щодо норм застосування Таегро™, то завдяки унікальному й досить агресивному штаму Bacillus amyloliquefaciens FZB24 вони надзвичайно низькі й становлять 0,185–0,37 кг/га для всіх зареєстрованих культур. Однак, зрозуміло, що в умовах закритого ґрунту на період використання Таегро™ вегетативна маса рослин може сягати понад 2 м. Саме тому для забезпечення ефективної роботи препарату варто дотримуватися концентрації робочого розчину не менше ніж 0,04%.

Оскільки Таегро™ є сухим біологічним препаратом, для забезпечення його ефективної роботи особливої ваги набуває правильне приготування робочого розчину.
Приготування робочого розчину:
1. Попередньо змішайте потрібну кількість Таегро™ (0,37 кг) у місткості з 2–5 л води.
2. Додайте половину кількості води в резервуар і почніть перемішувати.
3. Повільно вилийте маточний розчин на фільтр, змиваючи суміш водою у резервуар.
4. Долийте воду, що лишилася, у резервуар.
Таегро™ додається в бакову суміш першим. За взаємодії з водою ендоспори активуються, починають ділитися й таким чином виробляти метаболіти з фунгіцидною активністю.
Рекомендована норма витрати робочого розчину:
• Ягідні культури ― 400–800 л/га;
• Овочі відкритого ґрунту ― 400–800 л/га;
• Овочі закритого ґрунту ― 800–900 л/га.
Для ефективної дії препарату потрібно забезпечити якісне вкриття всієї рослини.
Зберігання
Ще однією перевагою Таегро™ є його препаративна форма (змочуваний порошок), що вигідно вирізняє його серед продуктів на ринку і дозволяє подовжити строк зберігання до 3 років (за збереження оптимальних температур і вологості) без втрати ефективності.
Підсумовуючи, можна сміливо стверджувати, що Таегро™ являє собою інноваційне та ефективне рішення для контролю сірої гнилі, борошнистої роси й інших захворювань як у тепличному виробництві, так і в умовах відкритого ґрунту. Завдяки унікальному механізму дії, високій екологічній адаптивності та безпеці цей біологічний фунгіцид відкриває нові можливості для сталого й ефективного захисту рослин. Використання Таегро™ не лише дозволяє виробникам ефективно контролювати захворювання, а й відповідає підвищеним вимогам споживачів щодо безпеки та екологічності сільськогосподарської продукції.
Галина ПАВЛЕНКО, менеджерка з технічної підтримки
засобів захисту овочів та картоплі, компанія «Сингента»





